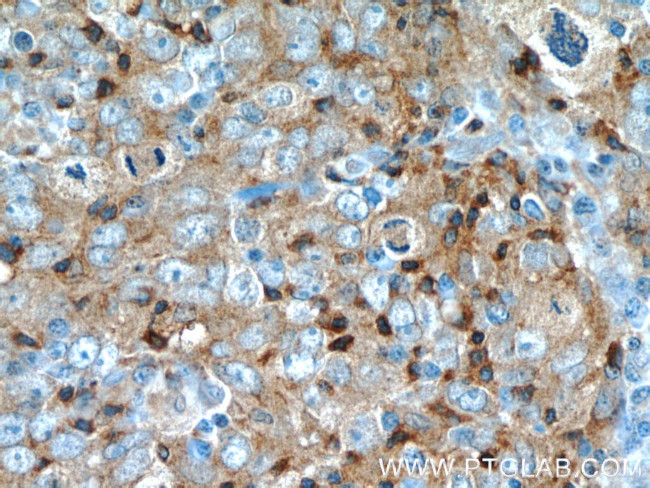
UGT8 Antibody in Immunohistochemistry (Paraffin) (IHC (P))

Search
Proteintech
UGT8 Polyclonal Antibody
{{$productOrderCtrl.translations['antibody.pdp.commerceCard.promotion.promotions']}}
{{$productOrderCtrl.translations['antibody.pdp.commerceCard.promotion.viewpromo']}}
{{$productOrderCtrl.translations['antibody.pdp.commerceCard.promotion.promocode']}}: {{promo.promoCode}} {{promo.promoTitle}} {{promo.promoDescription}}. {{$productOrderCtrl.translations['antibody.pdp.commerceCard.promotion.learnmore']}}
产品信息
17982-1-AP
种属反应
已发表种属
宿主/亚型
分类
类型
抗原
偶联物
形式
浓度
规格
纯化类型
保存液
内含物
保存条件
运输条件
产品详细信息
This antibody specifically recognizes the endogenous UGT8.
Immunogen sequence: FKTLASALH ERGHHTVFLL SEGRDIAPSN HYSLQRYPGI FNSTTSDAFL QSKMRNIFSG RLTAIELFDI LDHYTKNCDL MVGNHALIQG LKKEKFDLLL VDPNDMCGFV IAHLLGVKYA VFSTGLWYPA EVGAPAPLAY VPEFNSLLTD RMNLLQRMKN TGVYLISRLG VSFLVLPKYE RIMQKYNLLP EKSMYDLVHG SSLWMLCTDV ALEFPRPTLP NVVYVGGILT KPASPLPEDL QRWVNGANEH GFVLVSFGAG VKYLSEDIAN KLAGALGRLP QKVIWRFSGP KPKNLGNNTK LIEWLPQNDL LGHSKIKAFL SHGGLNSIFE TMYHGVPVVG IPLFGDHYDT MTRVQAKGMG ILLEWK (38-402 aa encoded by BC075069)
靶标信息
UGT8 (UDP-galactose-ceramide galactosyltransferase, 2-hydroxyacylsphingosine 1-beta-galactosyltransferase) is a 541 amino acid, single pass membrane protein of the UDP-glycosyltransferase family. UGT8 is believed to be primarily involved with the metabolism of sphingolipids and galactosylceramide biosynthesis. UGT8 is one of six genes whose elevated expression has been correlated with a significantly increased the risk of lung metastases in breast cancer patients. As such, UGT8 may be a significant index of tumor aggressiveness and a potential marker for the prognostic evaluation of lung metastases in breast cancer. UGT8 is ubiquitously expressed with highest levels found in central and peripheral nervous systems and is up-regulated in breast cancers.
仅用于科研。不用于诊断过程。未经明确授权不得转售。
生物信息学
蛋白别名: 2-hydroxyacylsphingosine 1-beta-galactosyltransferase; Ceramide UDP-galactosyltransferase; Cerebroside synthase; CGalT; UDP galactosyltransferase 8; UDP galactosyltransferase 8A; UDP-galactose-ceramide galactosyltransferase; UDP-galactose-ceramide galactosyltransferase 8; UDP-galactose-ceramide galactosyltransferase 8A; UDP-glucuronosyltransferase 8; unnamed protein product; uridine diphosphate glycosyltransferase 8
基因别名: AI850488; AW455908; CGT; mCerGT; UGT4; UGT8; Ugt8a
UniProt ID: (Human) Q16880, (Rat) Q09426, (Mouse) Q64676
Entrez Gene ID: (Human) 7368, (Rat) 50555, (Mouse) 22239